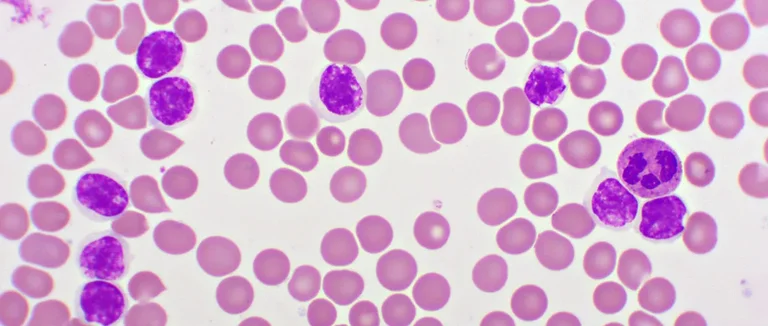

Qu'est-ce que la Leucémie Lymphoblastique Aiguë (LLA)?
-
Définition et Aperçu de la Leucémie Lymphoblastique Aiguë
-
Types de Leucémie Lymphoblastique Aiguë
-
Épidémiologie du Cancer de la Leucémie Lymphoblastique Aiguë
-
Facteurs de Risque et Causes
-
Signes et Symptômes
-
Processus de Diagnostic
-
Approches Thérapeutiques
-
Pronostic et Taux de Survie
-
Conclusion
-
FAQ

La Leucémie Lymphoblastique Aiguë (LLA) est un type de leucémie qui se développe vite dans la moelle osseuse. Elle touche surtout les cellules lymphoïdes. C'est l'un des cancers du sang les plus agressifs.
Cette maladie frappe surtout les enfants, surtout ceux de 2 à 5 ans. Mais elle peut aussi toucher les adultes. La LLA cause une prolifération anormale de cellules immatures dans la moelle osseuse. Cela perturbe la production normale des cellules sanguines.
Chez Liv Hospital, nous savons l'importance d'un diagnostic et d'un traitement précoces. Nous offrons des soins spécialisés et une prise en charge globale pour les patients atteints de LLA.
Points clés à retenir
● La LLA est une leucémie à progression rapide.
● Elle affecte principalement les enfants.
● Un diagnostic précoce est crucial.
● Les soins spécialisés sont essentiels pour le traitement.
● Liv Hospital offre une prise en charge globale.
Définition et Aperçu de la Leucémie Lymphoblastique Aiguë
La Leucémie Lymphoblastique Aiguë (LLA) est un cancer du sang. Il se caractérise par la prolifération de lymphocytes immatures. Cette maladie est très grave et demande un traitement rapide.
La LLA se développe à partir de lymphocytes immatures. Ces cellules ne fonctionnent pas bien. Elles s'accumulent dans la moelle osseuse et le sang, perturbant la production de cellules sanguines normales.
Origine Cellulaire et Développement
L'origine de la LLA est liée à une anomalie dans les cellules souches hématopoïétiques. Ces cellules produisent toutes les cellules sanguines, y compris les lymphocytes. Une mutation génétique peut provoquer une prolifération incontrôlée de ces lymphocytes immatures.
Le développement de la LLA implique des mutations génétiques. Ces mutations affectent la croissance et la survie des cellules lymphoïdes. Elles peuvent être causées par des facteurs génétiques ou environnementaux.
Impact sur le Système Sanguin
La LLA affecte le système sanguin de manière significative. L'accumulation de cellules lymphoblastiques anormales réduit la production de cellules sanguines normales. Cela provoque des symptômes comme l'anémie, les infections et les saignements.
La LLA se divise en deux types principaux : la LLA à cellules B et la LLA à cellules T. La LLA à cellules B est la plus fréquente, représentant environ 80-85% des cas.
Types de Leucémie Lymphoblastique Aiguë

La Leucémie Lymphoblastique Aiguë se divise en deux types principaux. Ces types dépendent des cellules lymphoïdes touchées. L'origine cellulaire influence l'approche de traitement et le pronostic.
LLA à Cellules B
La LLA à cellules B touche environ 85% des enfants et une grande partie des adultes. Elle affecte les cellules B immatures. On divise ce type en sous-types selon des caractéristiques génétiques et moléculaires.
Les avancées récentes ont amélioré les chances de guérison. Le taux de survie à 5 ans pour ceux diagnostiqués entre 2013 et 2019 est de 71,3%. Cela montre une amélioration notable dans le traitement.
LLA à Cellules T
La LLA à cellules T est moins commune, représentant environ 15% des cas chez les enfants et plus chez les adultes. Elle touche les cellules T immatures. Ce type est souvent associé à des caractéristiques uniques.
Le traitement de la LLA à cellules T est plus intense. Cela est dû à un pronostic moins favorable que celui de la LLA à cellules B. Mais, les progrès dans les thérapies ciblées ont amélioré les résultats pour ces patients.
| Caractéristiques | LLA à Cellules B | LLA à Cellules T |
| Fréquence chez les enfants | Environ 85% | Environ 15% |
| Fréquence chez les adultes | Proportion significative | Proportion plus élevée que chez les enfants |
| Cellules d'origine | Cellules B immatures | Cellules T immatures |
| Approche thérapeutique | Chimiothérapie standard | Approche plus intensive |
Épidémiologie du Cancer de la Leucémie Lymphoblastique Aiguë
La Leucémie Lymphoblastique Aiguë (LLA) est un cancer fréquent chez les enfants. Elle représente environ 30% des cancers chez les jeunes.
Nous allons voir les points clés de l'épidémiologie de la LLA. Cela inclut son incidence, sa prévalence, sa distribution par âge et les facteurs démographiques.
Incidence et Prévalence
On estime que 6 100 nouveaux cas de LLA seront diagnostiqués aux États-Unis en 2025. Cela montre l'importance de la recherche et de la sensibilisation.
La prévalence de la LLA dépend de l'âge et de facteurs démographiques. Les traitements actuels offrent de bonnes chances de guérison, ce qui augmente les taux de prévalence.
Distribution par Âge
La LLA touche surtout les enfants, avec un pic d'incidence entre 2 et 5 ans. Les adultes peuvent aussi être touchés, mais moins fréquemment.
Cette distribution par âge est cruciale pour les stratégies de dépistage et de traitement.
Facteurs Démographiques
Des facteurs démographiques comme le sexe, l'origine ethnique et la localisation géographique influencent l'incidence de la LLA. Par exemple, des différences existent entre les populations urbaines et rurales.
Comprendre ces facteurs est essentiel pour améliorer la santé publique et les résultats pour les patients.
Facteurs de Risque et Causes
La Leucémie Lymphoblastique Aiguë est une maladie complexe. Ses causes exactes sont encore peu connues. Mais, certains facteurs de risque ont été identifiés. Nous allons explorer ces facteurs pour mieux comprendre cette maladie.
Facteurs Génétiques
Les facteurs génétiques sont très importants dans le développement de la LLA. Certaines anomalies génétiques peuvent augmenter le risque. Les syndromes génétiques comme le syndrome de Down sont associés à un risque plus élevé.
Des études montrent que les antécédents familiaux de leucémie peuvent augmenter le risque. Cela suggère une composante héréditaire dans certains cas.
Facteurs Environnementaux
Les facteurs environnementaux jouent aussi un rôle dans le risque de développer la LLA. L'exposition aux radiations ionisantes augmente le risque. Cela inclut les accidents nucléaires et certaines procédures médicales.
Certaines expositions chimiques, comme les pesticides et les solvants, sont aussi associées à un risque accru. Il est crucial de minimiser l'exposition à ces substances dangereuses.
Conditions Médicales Préexistantes
Certaines conditions médicales préexistantes peuvent augmenter le risque de développer la LLA. Les personnes ayant subi une chimiothérapie ou une radiothérapie pour d'autres cancers ont un risque plus élevé. Cela inclut les maladies du sang préexistantes, comme les syndromes myélodysplasiques.
Une surveillance médicale étroite est essentielle pour les personnes ayant ces conditions. Cela peut aider à détecter les signes précoce de la LLA.
En résumé, bien que les causes exactes de la LLA restent mal comprises, des facteurs génétiques, environnementaux et médicaux jouent un rôle. Une meilleure compréhension de ces facteurs peut aider à améliorer la prévention et le traitement.
Signes et Symptômes
La Leucémie Lymphoblastique Aiguë (LLA) montre plusieurs signes. On peut voir des saignements de gencives, des douleurs osseuses, de la fièvre et une fatigue qui dure. Ces signes sont souvent les premiers à indiquer la maladie.
Manifestations Cliniques Communes
Les personnes atteintes de LLA ont plusieurs symptômes. Voici quelques-uns :
● Saignements des gencives et autres hémorragies inhabituelles
● Douleurs osseuses et articulaires
● Fièvre et infections fréquentes
● Fatigue et faiblesse générale
Ces symptômes peuvent sembler similaires à d'autres maladies. Mais si ils durent et se combinent, cela peut indiquer une LLA.
Différences entre LLA Pédiatrique et Adulte
Les symptômes de la LLA varient selon l'âge. Les enfants ont souvent des douleurs osseuses sévères et des infections fréquentes.
Les adultes, eux, peuvent avoir une fatigue qui dure et une perte de poids inexplicable. Les adultes ont aussi plus de chances d'avoir des anomalies génétiques complexes. Cela peut changer le pronostic.
"La reconnaissance précoce des signes et symptômes de la LLA est cruciale pour un diagnostic et un traitement rapides, améliorant ainsi les chances de survie."
Processus de Diagnostic
Pour diagnostiquer la LLA, les médecins utilisent des tests sanguins, une biopsie de moelle osseuse et des analyses cytogénétiques. Ces examens aident à savoir si vous avez la LLA et quel type. Ils sont aussi cruciaux pour choisir le meilleur traitement.
Examens Sanguins
Les premiers tests pour la LLA sont des examens sanguins. Ils mesurent :
● La numération globulaire complète pour voir si les cellules sanguines sont normales.
● Des marqueurs tumoraux pour trouver des cellules leucémiques.
Si ces tests montrent quelque chose d'anormal, il faut faire plus d'examens.
Biopsie de Moelle Osseuse
La biopsie de moelle osseuse est très importante pour le diagnostic. Elle prend un échantillon de moelle osseuse, souvent de l'os iliaque. Cet examen permet de :
● Voir si il y a des cellules leucémiques dans la moelle.
● Comprendre combien de cellules anormales il y a.
Tests Cytogénétiques et Moléculaires
Les tests cytogénétiques et moléculaires examinent les cellules leucémiques. Ils aident à :
Reconnaître les anomalies chromosomiques liées à la LLA.
Trouver les mutations génétiques qui influencent le traitement.
Ces infos sont essentielles pour un traitement personnalisé et efficace.
Approches Thérapeutiques
Le traitement de la LLA demande une approche à plusieurs niveaux. Cela inclut la chimiothérapie, les thérapies ciblées et la greffe de cellules souches. Nous allons voir comment ces méthodes aident à combattre la LLA.
Chimiothérapie Multi-agents
La chimiothérapie multi-agents est essentielle pour traiter la LLA. Elle utilise plusieurs médicaments pour tuer les cellules leucémiques. Cela aide à cibler les cellules cancéreuses à différents stades, rendant le traitement plus efficace.
Les traitements chimiothérapeutiques pour la LLA ont trois phases:
● La phase d'induction vise une rémission complète.
● La phase de consolidation élimine les cellules leucémiques restantes.
● La phase de maintenance prévient les rechutes.
Thérapies Ciblées
Les thérapies ciblées sont une avancée majeure dans le traitement de la LLA. Elles visent spécifiquement les cellules cancéreuses grâce à leurs caractéristiques moléculaires. Par exemple, les inhibiteurs de la tyrosine kinase sont utilisés pour certains patients.
Les avantages des thérapies ciblées sont:
Elles sont plus efficaces contre les cellules leucémiques.
Elles causent moins d'effets secondaires que la chimiothérapie traditionnelle.
Greffe de Cellules Souches
La greffe de cellules souches est une option importante pour certains patients de LLA. Cela inclut ceux à haut risque de rechute ou ceux qui ne répondent pas bien aux autres traitements.
Il existe deux types principaux de greffe de cellules souches:
● La greffe allogénique, où les cellules souches viennent d'un donneur.
● La greffe autologue, où les cellules souches viennent du patient lui-même.
Chaque type de greffe a ses avantages et risques. Le choix dépend de plusieurs facteurs, comme l'âge du patient et l'état de santé.
Pronostic et Taux de Survie
Comprendre le pronostic et les taux de survie est essentiel pour ceux atteints de Leucémie Lymphoblastique Aiguë (LLA). Les avancées dans les traitements ont changé le pronostic. Elles ont aidé à mieux comprendre la maladie.
Facteurs Influençant le Pronostic
Plusieurs éléments influencent le pronostic des patients LLA. Parmi eux :
● l'âge du patient au moment du diagnostic
● la réponse initiale au traitement
● la présence de certaines anomalies cytogénétiques
● la présence de maladie résiduelle minime après le traitement initial
Les patients plus jeunes ont généralement un meilleur pronostic. Une bonne réponse au traitement initial est aussi un bon signe.
Statistiques de Survie Actuelles
Les statistiques de survie pour la LLA ont beaucoup progressé. Pour les personnes diagnostiquées entre 2013 et 2019, le taux de survie à 5 ans est de 71,3%. Cela montre les progrès dans le traitement et la prise en charge de la maladie.
Avancées Récentes Améliorant les Résultats
Les avancées récentes dans le traitement de la LLA ont amélioré les résultats. Parmi ces avancées :
l'utilisation de thérapies ciblées qui s'attaquent spécifiquement aux cellules leucémiques
l'amélioration des protocoles de chimiothérapie
les greffes de cellules souches qui offrent une option de traitement intensif pour certains patients
Ces progrès ont augmenté les taux de survie. Ils ont aussi amélioré la qualité de vie des patients atteints de LLA.
Conclusion
La leucémie lymphoblastique aiguë (LLA) est une maladie grave qui demande un traitement rapide. Nous avons exploré les aspects clés de cette maladie, de sa définition aux traitements possibles.
Il est crucial de prendre en charge les patients de manière globale. Les progrès récents dans le traitement donnent de l'espoir pour de meilleurs résultats. La LLA est une maladie complexe qui nécessite une approche multidisciplinaire pour les meilleurs soins.
Nous nous engageons à offrir des soins de classe mondiale aux patients internationaux. Notre équipe est dédiée à fournir des soins de haute qualité, adaptés aux besoins de chaque patient.
En bref, l'ALL summary souligne l'importance de la recherche et des avancées médicales. Nous voulons contribuer à cette mission en offrant des soins exceptionnels et un soutien personnalisé.
FAQ
Qu'est-ce que la Leucémie Lymphoblastique Aiguë (LLA) ?
La LLA est un cancer du sang qui se développe dans la moelle osseuse. Elle se caractérise par la production excessive de lymphocytes immatures, appelés lymphoblastes.
Quels sont les principaux types de LLA ?
Il existe deux principaux types de LLA. Le premier est la LLA à cellules B. Le second est la LLA à cellules T, selon le type de lymphocytes affectés.
Quels sont les facteurs de risque de la LLA ?
Les facteurs de risque incluent les antécédents génétiques. Ils comprennent aussi l'exposition à certaines substances chimiques et les conditions médicales préexistantes.
Quels sont les signes et symptômes courants de la LLA ?
Les symptômes courants incluent les saignements des gencives et les douleurs osseuses. On peut aussi ressentir de la fièvre et de la fatigue.
Comment la LLA est-elle diagnostiquée ?
Le diagnostic utilise des examens sanguins et une biopsie de la moelle osseuse. Des tests cytogénétiques et moléculaires sont également nécessaires.
Quels sont les traitements disponibles pour la LLA ?
Les traitements incluent la chimiothérapie multi-agents. On utilise aussi des thérapies ciblées et la greffe de cellules souches.
Quel est le pronostic pour les patients atteints de LLA ?
Le pronostic dépend de plusieurs facteurs. Cela inclut l'âge, le type de LLA et la réponse au traitement.
Quels sont les taux de survie actuels pour la LLA ?
Les taux de survie ont amélioré grâce aux avancées dans les traitements. Cela inclut la chimiothérapie et les thérapies ciblées.
Qu'est-ce que la chimiothérapie multi-agents ?
La chimiothérapie multi-agents utilise plusieurs médicaments. Ces médicaments visent à tuer les cellules cancéreuses.
Qu'est-ce qu'une greffe de cellules souches ?
Une greffe de cellules souches remplace la moelle osseuse endommagée. Elle l'échange contre des cellules saines.
* Le contenu de notre site web est uniquement destiné à des fins d'information. Veuillez consulter votre médecin pour obtenir un diagnostic et un traitement. Le contenu de la page ne contient pas d'informations sur les services de santé thérapeutiques de l'hôpital Liv. .